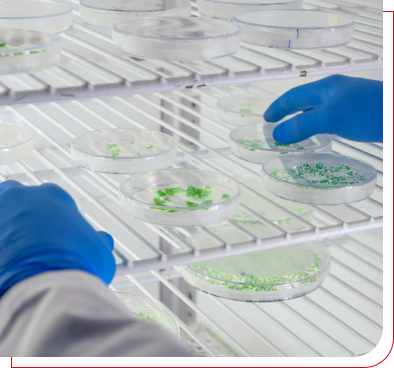

¡Hacemos la logística de tu empresa más simple, rápida y eficiente!
Envíos puerta a puerta
Brindamos un servicio logístico integral y personalizado: nos encargamos de todo, desde el retiro de paquetes en tu domicilio hasta la entrega final, siempre adaptándonos a tus necesidades.
¿Qué te ofrecemos?









Servicios internacionales
Facilitamos el comercio global con soluciones logísticas eficientes y personalizadas, asegurando que puedas enviar productos desde Argentina hacia el resto del mundo o recibir productos desde cualquier país, de manera rápida y segura.
- 01 Servicio para Tiendas Online, Marketplaces y Consolidadoras Globales
- 02 Servicio Courier Puerta a Puerta para Documentos, Muestras y Paquetes
- 03 Air Freight & Sea Freight Cargo



USalud
USALUD, nuestra unidad especializada Pharma y Beauty; dedicada a brindar soluciones logísticas de alta calidad para la industria farmacéutica, productos regulados de salud humana.
Ubicada estratégicamente, la planta operativa se encuentra Habilitada por ANMAT y SENASA, Certificados en Buenas Prácticas de Almacenamiento, Distribución y Transporte de medicamentos, garantizamos la seguridad y el cumplimiento de todos los requisitos exigidos por la Disposición 2069/18 y GLN.
- 01 Soluciones en almacenamiento en condiciones controladas
- 02 Áreas especializadas dentro de nuestras instalaciones
- 02 Distribución y transporte nacional

Gestión de almacenes flexibles a las necesidades de los distintos productos regulados tanto de especialidades medicinales como productos médicos, higiénicos, alimenticios, cosméticos, reactivos de diagnósticos.

Nuestras flotas trasladan de forma segura los productos de sanidad humana y cosméticos.
Warehousing y fulfillment
Nuestro depósito está ubicado en la Ciudad de Buenos Aires y tiene un espacio de 30.000 m² y más de 20.000 posiciones de almacenamiento, ideal para la guarda y gestión eficiente de tu stock.
¿Qué te brindamos?

Servicio postal especializado
- 01 Acuse de recibo
- 02 Carta Documento
- 03 Gestión de Documentación
- 04 Logística de Documentación Comercial








